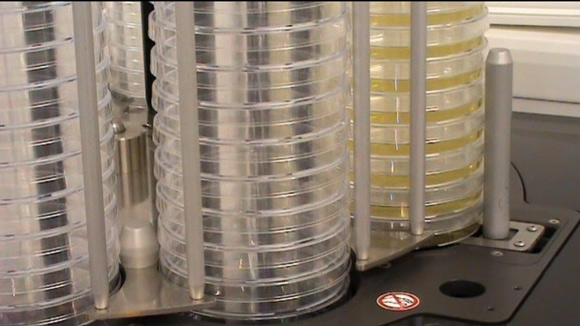
INTEGRA推出全新Turbo模式 大大提高MEDIAJET分裝效率

培養基制備實驗室現在使用 INTEGRA 推出的全新 Turbo 模式選件,不僅大大提高了 MEDIAJET 自動培養皿分裝系統的填充速率,而且節省了 40% 以上的時間。 憑借此選件,MEDIAJET 可設置高通量培養皿分裝的新填充速率標準。
MEDIAJET Turbo 模式下,實驗室每小時最多可分裝 1100 個培養皿或大量培養基的深度培養皿(每個培養皿最多 60ml),從而提高了生產率和操作靈活度,F有 MEDIAJET 培養皿分裝系統用戶只需更新到固件版本 (V02.10) 并購買 Turbo 模式套件即可享受此新功能。
MEDIAJET 自動培養皿分裝系統具備高度可靠性和全自動性能,大大減少了傳統培養皿分裝系統出現的操作停機時間和花費的勞動力成本。獨特的培養基分發功能充分利用流通的培養基,確保培養基均勻分布,表面平整。相比傳統系統,仔細調整每個培養皿中的培養基水平最多可節省 30% 的培養基用量。
要了解 MEDIAJET Turbo 模式選項的詳情,請訪問 www.integra-biosciences.com/mail/2011_12_05_Launch_MJ_Turbo-mode/MEDIAJET_Turbo_mode.WMV 或垂詢 INTEGRA,致電 +41-81-286-9530 或電郵 info@integra-biosciences.com(歐洲/亞太地區)或致電 +1-603-578-5800 或電郵 contact@viaflo.com(北美/南美)。